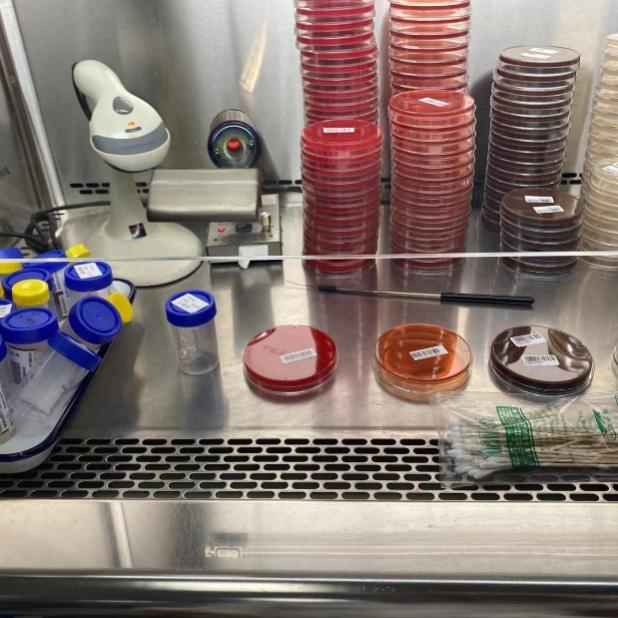

疫情就是命令,防控就是责任。一份核酸检测结果,是疫情研判的重要依据,也是许多人出行的“通行证”、回家的“定心丸”。而每一份看似简单的核酸检测结果背后,是一群检验人分秒必争、日夜坚守的结果。他们是面对病毒最近的“战士”,是新冠疫情歼灭战中的“排雷兵”,在医学技术学院就有这样几位新“检验人”。疫情当下,奋勇前行,医学技术学院王懿菲、徐立、袁鑫怡、张简润等四位学子的积极行动得到了上海市第十人民医院检验科全体人员的高度赞扬,特此发来了感谢信(图1)。

(图1、第十人民医院检验科感谢信)
我们的学生如是说:
王懿菲(图2):近期我在分子和免疫组工作。在分子组期间由于老师们都在忙着核酸检测,我主要负责淋巴细胞亚群的检测。首先对样本进行编号和分类,其次在老师加完样之后完成洗涤、加试剂和上机等步骤。在免疫组期间,我的任务是完成过敏源的检测和CRP的检测。自从疫情进入高发期以来,检验科的老师们都承受着巨大压力,经常加班。我作为检验科的实习生,能够用我的绵薄之力分担老师们一些压力,也学习到了检验人的精神,同时更加坚定了我成为检验人的目标。

图2、王懿菲在分子和免疫组工作
徐立(图3):我在急诊体液窗口实习,主要是接收标本、编号离心、打印报告等,及时解决患者检验需求问题。科室老师亲切和蔼,耐心教我们工作。

图3:徐立(左)做急诊体液检验工作
袁鑫怡(图4):最近的工作内容就是在门诊窗口为病人抽血。佩戴N95口罩是真的好闷,带着帽子和面屏的时候给抽血增加了很多难度。但是想到忙于核酸检测的老师还需要在此基础上穿上大白服装,真的感受到自己专业在疫情期间的重要性。向那些在抗疫一线战斗的医务工作者致敬,同时也希望自己以后可以成为一名合格的检验人。

图4:袁鑫怡在门诊检验岗位上工作
张简润:目前在急诊工作,主要负责为患者抽血、验收血液、体液标本以及血常规、生化、凝血等项目的上机操作。在疫情期间,急诊检验科扮演着一个很重要的角色,我很荣幸能为十院、上海献出我绵薄的一份力。刚到急诊时,我面对快节奏的工作状态显得十分手忙脚乱,来不及等我适应,就需要我全身心投入工作的状态中,我也在老师的教导和自己的摸索中,自己慢慢熟练起来,非常感谢老师。
“乌云不可遮月,疫情不可挡春”,冬去春会来,检验人向“疫”而行,他们是坚守岗位的幕后“大白”,在疫情防控中不忘初心,砥砺前行,贡献自己的一份光与热,只为坚决打赢这场疫情防控战!
(医学技术学院)













